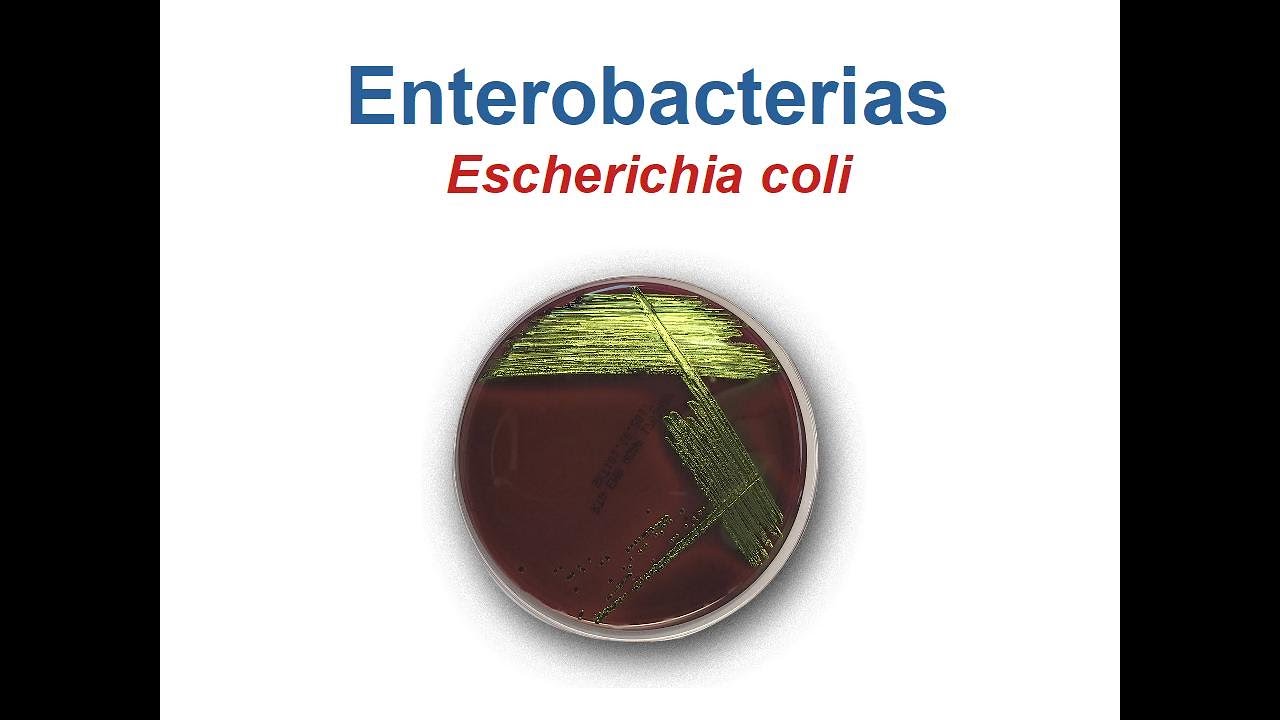

entonces en el estudio de la microbiología es prioritario hablar de aquellas infecciones que son comunes y frecuentes en el escenario clínico desde luego cuando estas pueden crear manifestaciones tan severas daño tan severo al cuerpo que comprometa el pronóstico a corto y a mediano plazo dicho eso entonces hablemos de uno de los microbios más populares de la microbiología estamos hablando de la escherichia coli escherichia colli como le quiera llamar comienzo su perfil básico nos indica que es una bacteria recuerda microorganismos que se dedican a invadir a destruir ya inflamar el tejido donde se posicionan descubierta en 1885 por el cazador de microbios theodore von escrich de donde claro deriva su nombre utilizando el método de gran la tinción de gran esta bacteria se pinta de rojo gran negativa y punto muy importante para la selección de la cntv en el tratamiento conocido como microorganismo anaerobio facultativo metaboliza y sobrevive con oxígeno y metaboliza y sobrevive sin oxígeno perteneciente a la familia de las enterobacterias al género script ya la especie coli muy importante la familia de la que deriva ya que muchos microbios que hemos visto en sesiones pasadas derivan de esta misma familia precisamente es un microbio invasor pero también considerado local lo cual lo convierte en un habitante de nuestro cuerpo que va a ser un oportunista si le das la oportunidad de atacar no dudará en hacernos daño en cuanto a su metabolismo y supervivencia utiliza la herramienta enzimática catalasa sin embargo carece de la oxidasa para poder llevar a cabo su metabolismo supervivencia y la fabricación de sus factores de patogenicidad la vía de transmisión siempre es importante el alimento contaminado es la principal fuente la principal vía de transmisión de esta bacteria la vía fecal-oral hay que tener mucho cuidado entonces con los alimentos con la preparación de los mismos y personal de la salud cuidado con la manipulación de secreciones potencialmente infectadas especialmente las evacuaciones este microbio es un fermentador exitoso de glucosa y de lactosa de hecho estas propiedades hacen que en los medios de cultivo por ejemplo en los que tienen medios para que hacer crecer a aerobios como lo sería el mar con key coli pueda crecer en este medio de mac con key y generar colonias de color rosado y su capacidad de fermentar lactosa hace que en el agar en el medio de cultivo de zinc azul de metileno la e. coli haga crecer colonias que se tiñen de un verde metálico bien fin del comercial entonces el humano es el único hospedador ninguna especie animal nos lo transmite ni tampoco compartimos la enfermedad con ninguna especie la mayoría de los infectados son portadores asintomáticos tomando en cuenta el hecho de que es una bacteria local debemos de tener en cuenta en qué punto la e. coli que vive en nuestro cuerpo se puede volver mal ha dicho eso si tú le preguntas a la e.
coli qué temperatura le gusta más para poder crecer y hacer daño te dirá que los 37 grados centígrados son de su agrado la forma que tiene esta bacteria es la forma de un bacilo no forma esporas como lo haría tétanos o el botulismo y esta puede reducir los nitratos a nitritos y puede reducir el indol a triptófano propiedades metabólicas que ayudan mucho a su detección en el laboratorio el factor tiempo siempre es importante amigos el tiempo de incubación desde que la bacteria malvada llega a mi cuerpo y comienzan las manifestaciones puede pasar hasta una semana qué lugares afecta a una vez que se decide atacar todos estos especial atención entonces en el tracto gastrointestinal en el tracto urinario y en cuanto al compromiso de la circulación sanguínea es una bacteria de distribución mundial de hecho causa una enfermedad conocida como la diarrea del viajero no importa qué parte del mundo te vayas siempre vas a encontrar pacientes afectados por esta bacteria y por último no hay vector intermediario no es como el dengue no es como el yersinia pestis no tiene insecto transportador sencillo entonces hablemos de la forma como mencionamos tiene una forma de bacilo otorgada por su pared bacteriana la cual se tiñe de rojo con el método de grant y al igual que otras bacterias en su interior tiene el citoplasma tiene ribosomas tiene cadena de adn y tiene fragmentos de esa cadena de adn formando formando círculos independientes a los que se les denomina plásmidos y al igual que otras muchas bacterias en su periferia alrededor de su pared presenta flagelos y fimbres que le ayudan desde luego a la mayor movilidad y a la mayor fijación en el tejido en el que va a hacer el daño dicho eso entonces como habíamos mencionado en los medios de cultivo la 'e coli' gusta de crecer siempre y cuando se mantenga una temperatura de 37 grados medios de cultivo más populares para hacer el crecimiento de este son el mar con ki y el austin azul de metileno dicho eso entonces hablemos de que la e. coli tiene muchas variedades tiene muchas líneas patogénicas por lo tanto hay que conocer de qué armas cortan estas principales líneas desde luego sus propiedades patológicas derivan de los antígenos las bacterias las líneas patológicas de la e. coli presentan propiedades en su estructura como el antígeno h presente principalmente en los flagelos y este tipo de antígeno es el que le permite la movilidad de tejido tejido y uno de los principales responsables de la resistencia en contra del sistema inmunitario no olvidemos que nuestros glóbulos blancos captarán la presencia del invasor e irán a luchar contra él la e.
coli cuenta con eso y tiene el antígeno h para permitirle una movilidad y también permitirle resistencia ante este embiste de los glóbulos blancos el antígeno que se encuentra en el lipopolisacárido estructura de la pared y de las líneas bacterianas que tienen cápsula de la e. coli está más relacionado con el choque séptico este tipo de lipopolisacáridos una vez regado a través del riego sanguíneo tiene la capacidad de crear disfunción aguda en el órgano en el que afecta si varios órganos son afectados al mismo tiempo entonces el colapso el colapso simultáneo llevará a un estado de choque el antígeno p que se encuentra principalmente en las simples en las vellosidades periféricas de la e. coli que le ayudan al amarre de los tejidos se relacionan principalmente con infecciones y daños en la vía urinaria tanto la vía urinaria superior como la vía urinaria inferior y por último el antígeno k1 que lo presentan las líneas patológicas de e.
coli que portan cápsula y éste se relaciona sobre todo con la agresividad de estas líneas de e. coli ante las bolsas meninges y a la hora de atacar la vía respiratoria inferior en el período neonatal si hay líneas patológicas de e. coli que agarran recién nacidos tema que vamos a abordar en pediatría claro está entonces además de estas propiedades anti higiénicas que las líneas patológicas de la e.
coli tienen también es muy importante tener en cuenta todas estas toxinas un montón de toxinas las cuales hacen a esta coli una de las bacterias más agresivas una de las bacterias más resistentes a tratamiento antibiótico y una de las bacterias que más resisten el embiste de nuestro sistema inmunitario no por nada también esas cualidades la hacen una de las bacterias mucho más estudiadas cuidado ahí entonces sobre todo personal de la salud la vía de contagio nosocomial siempre siempre estará presente y debemos minimizar los factores de riesgo en especial mucho mucho especial atención en los hábitos higiénicos dicho eso entonces como habíamos mencionado la escherichia coli e un habitante del tracto gastrointestinal es decir es una bacteria local en algún punto nuestro tracto gastrointestinal especialmente intestino delgado e intestino grueso fueron colonizados por la 'escherichia coli' entonces es aquí donde dice oh no oiga profe si tenemos todos o la mayoría de la población tenemos coli en nuestro intestino delgado y en nuestro intestino grueso quiere decir que es una bacteria local desde luego es parte de la flora intestinal de las personas y como flora intestinal ayuda en diversas funciones fisiológicas como lo sería la digestión y la formación de vitamina k tajam entonces la duda aquí es ok cuando se vuelve mala la e. coli vive dentro de mí me está ayudando a digerir me está ayudando a tener vitamina k entonces cuando se vuelve malvada bueno se vuelve malvada porque porque en tu intestino delgado intestino grueso predominantemente la e. coli se encuentra constante división tiene una multiplicación muy rápida entonces mientras más se multiplica la e.
coli más propiedades patogénicas adquiere mientras más se multiplica mientras más se reproduce en tu intestino más probabilidades hay de que salgan versiones malas versiones patológicas oiga profe y entonces quiere decir que ahorita en mi intestino delgado intestino grueso hay eco y en reproducción ajá quiere decir que si crece demasiado se va a volver mala contra mí no cómo es eso bueno no olvidemos que tú tienes un sistema de defensa estos glóbulos blancos el sistema inmune le pone un estate quieto a la e. coli de tu intestino le dice la école y estás creciendo de más para de ahí porque si no te vas a volver patogénica y eso no lo voy a permitir además las otras bacterias que se encuentran en tu flora intestinal como los lactobacilos por ejemplo también le dicen a la e coli e. coli no crezca además nos va aquí el ambiente porque école y si creces mucho vas a sacar versiones patogénicas esta persona sabe enfermar va a tomar antibiótico y nos vas a matar de paso a nosotros así que estate quieta e.
coli entonces esos dos puntos en el intestino delgado intestino grueso de portadores hace que la e. coli no se vuelva patológica por una excesiva multiplicación pero pero pero nada evita que algunas versiones patológicas algunas versiones malas que sí alcanzaron a sobre crecer nada impide que éstas se vayan por las evacuaciones por lo tanto en la persona portadora de la e. coli intestinal no le va a hacer ningún daño pero el sobre crecimiento de esta bacteria que alcance a salir con las evacuaciones si va a ser patogénico para una tercera persona es decir si del intestino de una persona salió en las evacuaciones versiones maléficas versiones malvadas de la e.
coli y esa persona contamina sus manos con esas evacuaciones contaminadas a su vez con la e. coli y así prepara el alimento pues obviamente el cliente la persona que coma ese alimento va a comer alimento contaminado con una versión mala de la e. coli mala para él pero en el dueño original no pasaba nada porque porque su sistema inmune su flora intestinal no dejaron que sobre crecer y lo enfermar entonces las versiones patogénicas de la e.
coli son malas para otra persona no para el dueño original bien dicho eso entonces fin de comercial como la e. coli acabamos de decir tiene una multiplicación excesiva una multiplicación rápida por eso da origen a varias líneas patológicas varias versiones patogénicas que las más populares son la e coli enteropatógena y acá la e coli enterotoxigénica entero invasiva enterohemorrágica también y sobre todo conocida como la línea o 157 diagonal h 7 la enteroagregativa y por último la y urológica entonces las principales líneas patogénicas que derivan de la multiplicación excesiva de la e. coli son estas estas al ser malvadas para otra persona hay que preguntar ok y cómo atar a cada una en general cuál es un método de ataque bien la e coli enteropatógena acá y enterotoxigénica tienen el mismo modo de ataque y eso es que que una vez posicionadas en el tracto gastrointestinal de la persona a la que van a infectar cuando llegan al intestino de una persona que comió alimento contaminado con evacuaciones de una coli patogénica esas e coli llegan al intestino de este paciente y dicen eh ya estamos posicionados en el tracto gastrointestinal de este paciente hora de liberar nuestras toxinas nuestras toxinas de adherencia nuestros factores que nos ayudarán a fijarnos al tejido nuestros antígenos y nuestras toxinas vamos a dañar este tejido y ese daño al tejido gastrointestinal patrocinado por la entero patogénica enterotoxigénica va a dar como resultado la pérdida de agua la pérdida de electrolitos y la mala digestión de alimentos que tener mucho cuidado porque porque estas herramientas patológicas de la e.
coli tanto patogénica como toxigénico se parecen mucho al mecanismo de acción del vibrio cholera es decir la estimulación vía adenilato ciclasa del intestino genera grandes pérdidas de electrolitos grandes pérdidas de líquidos mala digestión lo cual puede llevar al paciente sin duda a una deshidratación un choque hipovolémico que tener mucho cuidado con ese aspecto lado tercera versión la entero invasiva es un poquito más brava que estas dos primeras estas dos primeras te generan deshidratación pérdida de electrolitos mala digestión de alimentos y claro tu sistema de defensa tu sistema inmunológico va a ir a luchar con ellas propiciando más inflamación propiciando más dolor propiciando más dificultad para la digestión y obviamente llevando las manifestaciones características que vamos a hablar más adelante bien entonces la entera invasiva tú le dices a tu entero invasiva tú qué haces bueno yo al llegar al tracto gastrointestinal de la persona a la que voy a infectar no me quedo fuera yo sí me meto a los tejidos yo si me meto al espacio intercelular yo si me meto directamente al tejido como tal a las células para despedazar las utilizo los mismos factores detox y genís y that pero pero pero como yo invado como yo ya entró directamente al tejido y lo destruyó voy a ocasionar diarrea pérdida de líquido pérdida de electrolitos pero también mi invasión puede generar pérdida sanguínea entonces un punto un síntoma agregado que yo entero invasiva puedo hacer es generar un sangrado de tubo digestivo bajo ok bien la siguiente tu enterohemorrágica o 157 h7 tú qué haces bueno la enterohemorrágica dice yo soy la más malvada de todas porque porque además de los principales agentes patogénicos toxinas que producen las demás yo produzco otras dos una que se llama toxina shiga y la otra se llama hemo licina por eso soy tan bravo ok entonces qué ocasionarás enterohemorrágica bueno yo no soy muy amable con el tejido gastrointestinal yo directamente lo destruyó lo acabo creo necrosis creo gangrena y eso va a generar desde luego pérdida de agua pérdida de electrolitos y sangrado vaya santo dios y que más vas a hacer bueno mediante las toxinas shiga iem o lisina que son el extra que yo tengo voy a generar pérdida y afección de las funciones renales en un síndrome que se llama síndrome hemolítico urémico te refieres con eso bueno mis toxinas dañan la filtración renal hacen y crean una insuficiencia renal aguda que de no corregirse puede llevar a un daño crónico otro punto este síndrome que yo causo se llama síndrome hemolítico porque porque yo hago que los glóbulos rojos sean despedazados como lo haces eso es por medio de la circulación yo en mis toxinas yo e coli enterohemorrágica generó una disminución de plaquetas las plaquetas las empiezo a hacer coágulo empiezo a hacer que se atoren formando coágulos no requeridos no requeridos adentro de la circulación para que cuando un glóbulo rojo pase por este tramo donde están un montón de plaquetas a pellizcadas un montón de plaquetas amontonadas cuando pase un glóbulo rojo por aquí quedé despedazado que de emol izado y de paso s esa formación de coágulos innecesarios en la circulación va a hacer que las plaquetas disminuyan vertiginosamente creando una condición denominada púrpura trombocitopénica trombótica es decir me a cabo todas las plaquetas del cuerpo creando coágulos innecesarios en la circulación que destruirán a su vez glóbulos rojos cuando estén pasando por allí generando anemia y generando disminución de plaquetas por lo tanto también riesgo de hemorragias internas eso aparte de la lesión en el riñón que generan mis toxinas vaya santo dios entonces tú si quieres brava e. coli enterohemorrágica pues se hizo de las más peligrosas desde luego bien oye tú e coli enteroagregativa tú la quinta tú qué haces bueno antes de continuar debo de advertir que la línea de la e. coli enterohemorrágica o157 h7 popularmente encontrar en los libros de microbiología que se encuentra sobre todo en carne de hamburguesa mal preparada carne de hamburguesa mal cocinada carne de hamburguesa contaminada con la bacteria cuidado en ese aspecto bien entonces la quinta línea la enteroagregativa básicamente funciona como las dos primeras la única el único detalle que tiene es que es muy aferrada al tejido se agrega y es muy trabajoso quitarla requiere de tratamiento antibiótico más prolongado bien y por último la última línea patogénica la e.
coli urológica que como su nombre lo dice principalmente va a afectar la vía urinaria tanto superior como inferior entonces en resumen la e. coli vive normalmente es una bacteria local de intestino delgado y grueso su sobre crecimiento crea lineas patológicas que normalmente no afectan al dueño pero si esas líneas patológicas salen con las evacuaciones y una segunda persona otra persona se alimentan toman alimentos contaminados con estas evacuaciones que tienen e colinversiones patogénicas entonces puede infectarse bien sencillo ah entonces hablemos pues de las manifestaciones la diarrea la deshidratación la distensión abdominal el dolor son lo típico pero también otras bacterias gastrointestinales pueden ocasionar lo las náuseas el vómito la intolerancia el alimento puede ser por el efecto de la deshidratación la hiper osmolaridad o el arribo de las toxinas de la e. coli al cerebro estimulando el centro del vómito y generando también empeoramiento de la deshidratación como ya habíamos mencionado el cerebro puede ser afectado ya sea por efecto directo de las toxinas de la e.
coli o por efecto secundario de la deshidratación y personalidad o por efecto de secundario de el acúmulo de asúa 2 que generaría la insuficiencia renal en el síndrome urémico hemolítico que causa la línea enterohemorrágica la disminución de peso desde luego por la mala digestión el mal aprovechamiento y absorción de los nutrientes de los alimentos sobre todo cuando la e. coli se mantiene de una manera crónica en el paciente y la anemia y trombocitopenia recuerda anemia hemolítica los glóbulos rojos quedan despedazados porque porque en la circulación en las arteriolas es donde las toxinas de la e. coli enterohemorrágica crearon coágulos con las plaquetas coágulos innecesarios que al momento de que el glóbulo rojo pasa a través de esos coágulos queda despedazado queda hemo lizado y eso de paso hace que las plaquetas se consuman en coágulos innecesarios y no estén disponibles para las verdaderas hemorragias creando entonces la condición que habíamos dicho que es la púrpura trombocitopénica trombótica riesgo de sangrados tanto externos como internos desde luego la vía urinaria puede afectarse ya sea por la línea euro lógica de la e.
coli o por la e. coli enterohemorrágica recuerda las toxinas del enterohemorrágica toxinas shiga emol y zinc a las toxinas termolábiles termoestables de la e. coli enterohemorrágica generan disfunción del riñón disfunción en el filtrado glomerular generan que los tóxicos que se supone que el riñón se debe de deshacer de se acumulen en el cuerpo y generen daño e intoxicación del mismo sobre todo al órgano que se intoxica inmediatamente con cualquier tóxico que no es desechado o sea el cerebro cuidado ahí muy importante también la vía urinaria inferior uretra y vejiga próstata también es blanco de ataque en especial con la línea euro lógica de la e.
coli las cistitis las prostatitis agudas casi siempre o en la mayoría de las ocasiones son patrocinadas por las líneas urológicas de la sequía coli desde luego la infección gastrointestinal llevará a pérdida de líquidos a choque hipovolémico a hemorragias a 11 raciones a perforaciones y a sobre infecciones bacterianas en especial cuidado con aquellos pacientes que tienen las defensas comprometidas muy importante también la e. coli se detecta mucho en los catéteres peritoneales sobre todo las personas que tienen diálisis a través de este medio hay que tener especial cuidado porque porque el catéter peritoneal con el que se llevan a cabo las diálisis frecuentemente es contaminado por la école y hay que tener mucho mucho especial atención en este tipo de pacientes como habíamos mencionado la presencia de las toxinas bacterianas adentro de la circulación además de consumir las plaquetas al formar coágulos innecesarios en la microcirculación para que los glóbulos blancos se despedacen al pasar también pueden hacer por medio de sus toxinas colapso de la presión arterial llevando entonces al choque séptico lo cual de no ser corregido a tiempo dar tratamiento prioritario puede llevar al deceso también como acabamos de mencionar una de las principales causas de prostatitis infecciosa y empeoramiento de la hiperplasia benigna de próstata de causa infecciosa es también la e. coli generando una de las principales urgencias urológicas en el varón que es la retención aguda de orina porque la próstata inflamada que ya estaba de por sí grande en el caso de la hiperplasia al inflamarse presiona y cierra aún más la uretra creando entonces esta situación de urgencia el cuidado ahí y principalmente en personas con defensas bajas pero más que nada en nenes en recién nacidos por ejemplo recién nacidos contaminados con evacuaciones de la mama no olvidemos en la sección de ginecología que cuando una mujer va a parto natural se recomienda un enema jabonoso para limpiar el intestino para que al momento de que el bebé nazca por vía vaginal no tenga el riesgo de ser contaminado con las evacuaciones de la mamá evacuaciones que sin duda pueden traer versiones patogénicas de la e.
coli que a la mamá no le afectaban pero al bebé si al bebé se le pueden ir directamente a los pulmones esta bacteria o directamente a las meninges y obviamente un recién nacido tiene poco entrenamiento su sistema inmunológico para defenderse y el riesgo de choque séptico de muerte neonatal es elevado cuidado ahí dicho eso hablemos de el diagnóstico amigos el diagnóstico como siempre es clínico lo que ve es lo que hoy es lo que toca si lo que percute es en el paciente pero sobre todo lo que interrogan las tecnologías sanguíneas en busca de los antígenos de la e. coli es muy muy buena herramienta para el diagnóstico el cultivo de evacuaciones el cultivo de secreciones potencialmente infectadas la tinción de grant el cultivo sanguíneo la búsqueda molecular a través del pcr son herramientas diagnósticas que se deben de tener en cuenta para llegar ver diagnosticar a la e. coli y dar tratamiento antes de que sea tarde pero pero pero nunca olvidemos que no todas las manzanas son verdes amigos tenemos que descartar todas estas porque pueden generar cuadros que simulan una infección por e.
coli sus versiones patogénicas pero también hay que actuar rápido porque porque las complicaciones no se van a esperar y mientras más vayan apareciendo más tratamiento de sostén vamos a tener que ofrecer a nuestro paciente antes de que estas complicaciones acaben con él o generen complicaciones pronóstico sombrío a corto y mediano plazo finalmente entonces el tratamiento consiste en tratamiento de sostén y si es pertinente se tiene que estar el uso de antibióticos desde luego hay versiones de la e. coli que pueden que pueden llegar y pasar del cuerpo sin la necesidad de antibiótico pero hay otras más patogénicas que sí requieren en este caso estos son los principales antibióticos con los que podemos eliminar a las versiones patogénicas de la e.